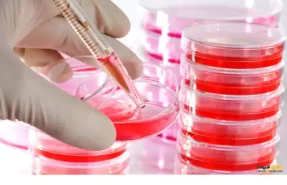

درباره ما
لورم ایپسوم متن ساختگی با تولید سادگی نامفهوم از صنعت چاپ، و با استفاده از طراحان گرافیک است، چاپگرها و متون بلکه روزنامه و مجله در ستون و سطرآنچنان که لازم است، و برای شرایط فعلی تکنولوژی مورد نیاز، و کاربردهای متنوع با هدف بهبود ابزارهای کاربردی می باشد، کتابهای زیادی در شصت و سه درصد گذشته حال و آینده، شناخت فراوان جامعه و متخصصان را می طلبد، تا با نرم افزارها شناخت بیشتری را برای طراحان رایانه ای علی الخصوص طراحان خلاقی، و فرهنگ پیشرو در زبان فارسی ایجاد کرد، در این صورت می توان امید داشت که تمام و دشواری موجود در ارائه راهکارها، و شرایط سخت تایپ به پایان رسد و زمان مورد نیاز شامل حروفچینی دستاوردهای اصلی، و جوابگوی سوالات پیوسته اهل دنیای موجود طراحی اساسا مورد استفاده قرار گیرد.
پارس پخش تهران
محصولات پارس پخش تهران
سوالات متداول پارس پخش تهران
استفاده از تجهیزات استریل مانند پلیت استریل، لوله گاما، یورین باتل و اپلیکاتور باعث میشود:
- دقت نتایج آزمایش افزایش یابد.
- آلودگیهای محیطی کاهش پیدا کند.
- از انتقال عفونتها جلوگیری شود.
- باید در محیط خشک و در دمای اتاق نگهداری شود.
- از باز کردن بستهبندی قبل از استفاده خودداری کنید تا استریلیته حفظ شود.
- پس از استفاده، دور انداخته شده و بازیافت نمیشود.
- از تماس مستقیم دست با نمونه جلوگیری کنید.
- مقدار کمی از مدفوع را با قاشقک داخل قوطی قرار دهید.
- درب را محکم ببندید و در دمای مناسب (معمولاً یخچال) نگهداری کنید تا برای آزمایش ارسال شود.

 پتری دیش
پتری دیش